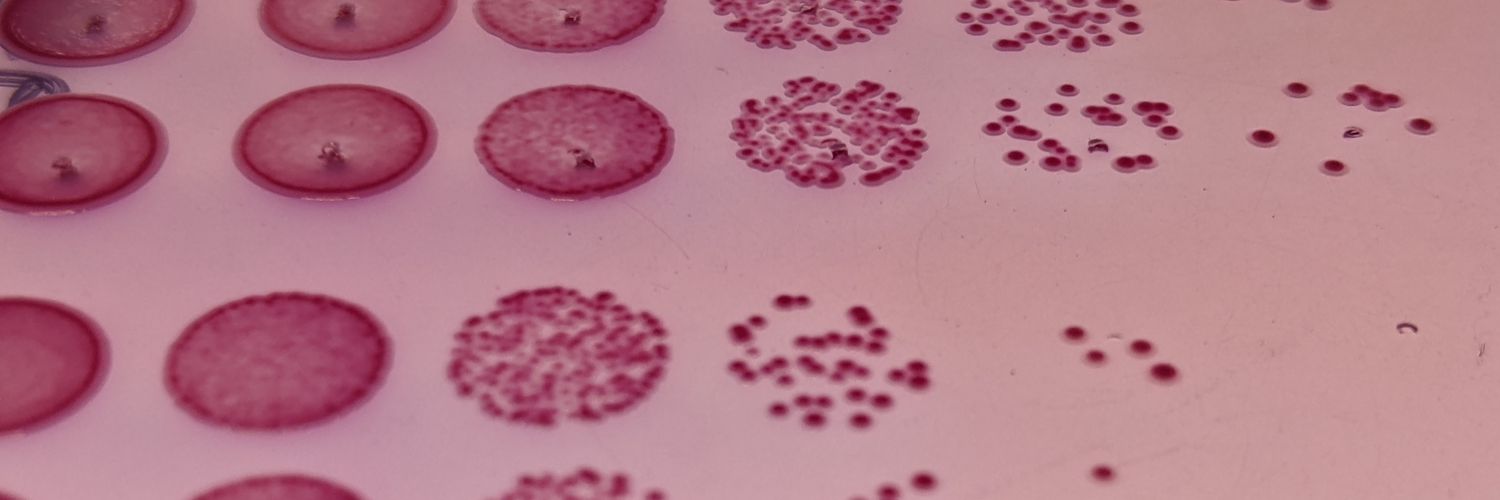
Grischa banner

Grischa
0 posts


Grischa
@grischachen
microbiologist @salkinstitute studying evolution of virulence in enteric pathogens
La Jolla, San Diego Katılım Temmuz 2022
52 Takip Edilen15 Takipçiler
Henüz tweet yok
Grischa
0 posts

@grischachen
microbiologist @salkinstitute studying evolution of virulence in enteric pathogens
Henüz tweet yok